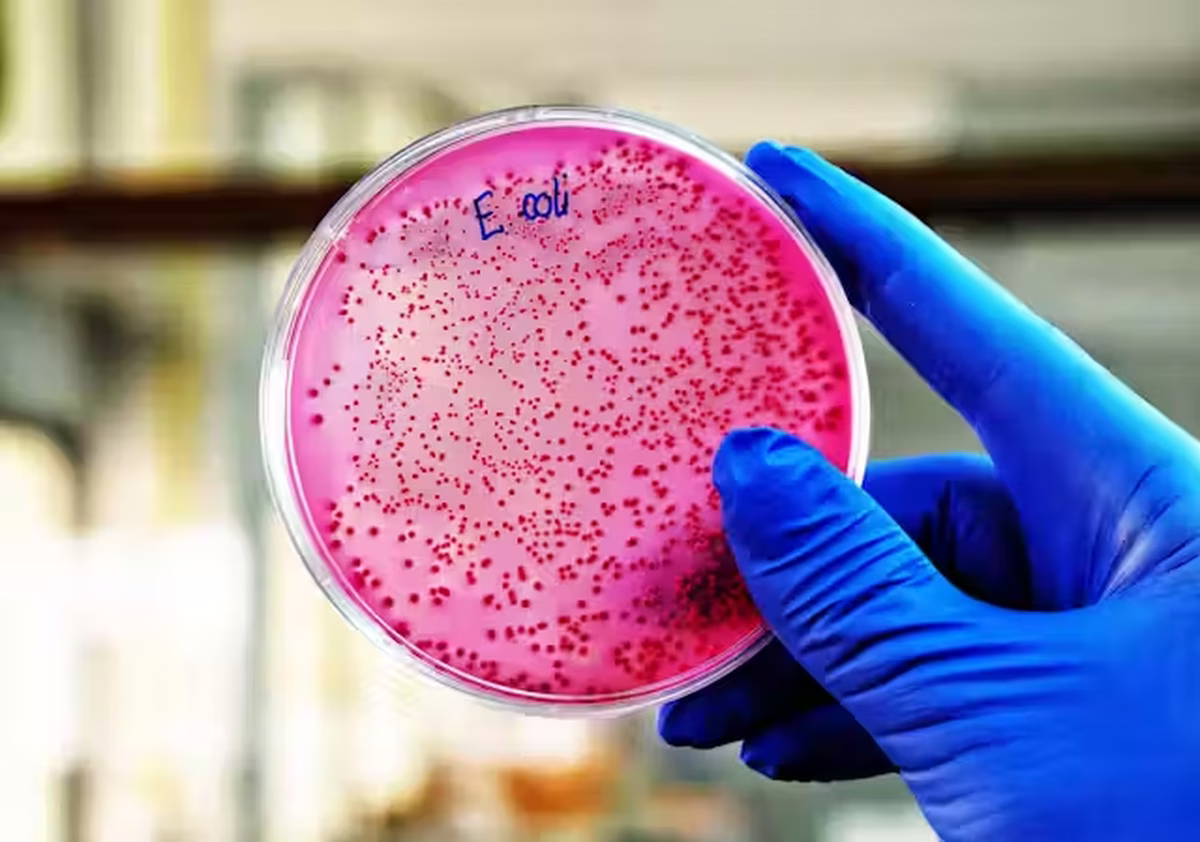
La bacteria E. coli puede causar infecciones graves y a veces mortales en niños pequeños, personas mayores y aquellas con sistemas inmunológicos debilitados. La bacteria E. coli puede causar infecciones graves y a veces mortales en niños pequeños, personas mayores y aquellas con sistemas inmunológicos debilitados.

Últimamente, muchos productos fueron retirados del mercado de Estados Unidos debido a que contienen bacterias que contaminan a los clientes. Esta vez le tocó un producto de Grimmway Farms, unas zanahorias fueron descubiertas con E. coli. Sigue leyendo para conocer más sobre este producto retirado.
Urgente: retira este producto contaminado de tu refrigerador
Este producto fue retirado del mercado de Estados Unidos debido a que contiene la bacteria E. coli, a continuación te contaremos más sobre estas zanahorias
►TE PUEDE INTERESAR: Los tres productos comestibles que están a mega oferta en Dollar Tree
El producto contaminado
Este nuevo brote infecto a miles de personas en Estados Unidos, todas ellas consumieron las zanahorias orgánicas envasadas. Una de las personas falleció a causa de infección.
El centro para el Control y la prevención de enfermedades notificó un total de 39 personas resultaron infectadas y 15 fueron hospitalizadas en 18 estados luego de consumir zanahorias orgánicas enteras o miniaturas vendidas por Grimmway Farms.
La empresa comunicó en su página web que ya ha retirado las zanahorias orgánicas entera o de miniatura vendida en bolsas bajo múltiples marcas, incluyendo 365, Cal-Organic, Nature’s Promise, O-Organics, Trader Joe’s y Wegmans, entre otras.
Estas zanahorias ya nos están distribuyendo, pero el centro para el Control y la Prevención de enfermedades ha advertido que no se coman las zanahorias retiradas y que se revisen sus refrigeradores en buscar de cualquier producto que coincida con la descripción.
La mayoría de las personas infectadas se encuentran en Nueva York, Minessota y Washington, seguidos por California y Oregon, aunque se reportaron infecciones en estados de todo el país.
►TE PUEDE INTERESAR: Qué hacer si compraste el talco que fue prohibido por la FDA
Un gran brote
En los últimos meses, ha habido un brote de E. coli. En octubre, más de 100 clientes de McDonald's se enfermaron debido a esta bacteria que se encontraba en las cebollas en tiras. En Reino Unido, una persona falleció en un brote por esta bacteria debido a la lechuga que enfermó a 275 personas. Además, unas nueces orgánicas enfermaron varios consumidores.
A pesar de todos los brotes, el suministro de los alientos es relativamente seguro, aunque la reducción de la bacteria no ha tenido mucho éxito. Estas zanahorias orgánicas fueron retiradas y tienen fecha de consumo preferentemente del 11 de septiembre al 12 de noviembre, según la Administración de Alimentos y Medicamentos de Estados Unidos.